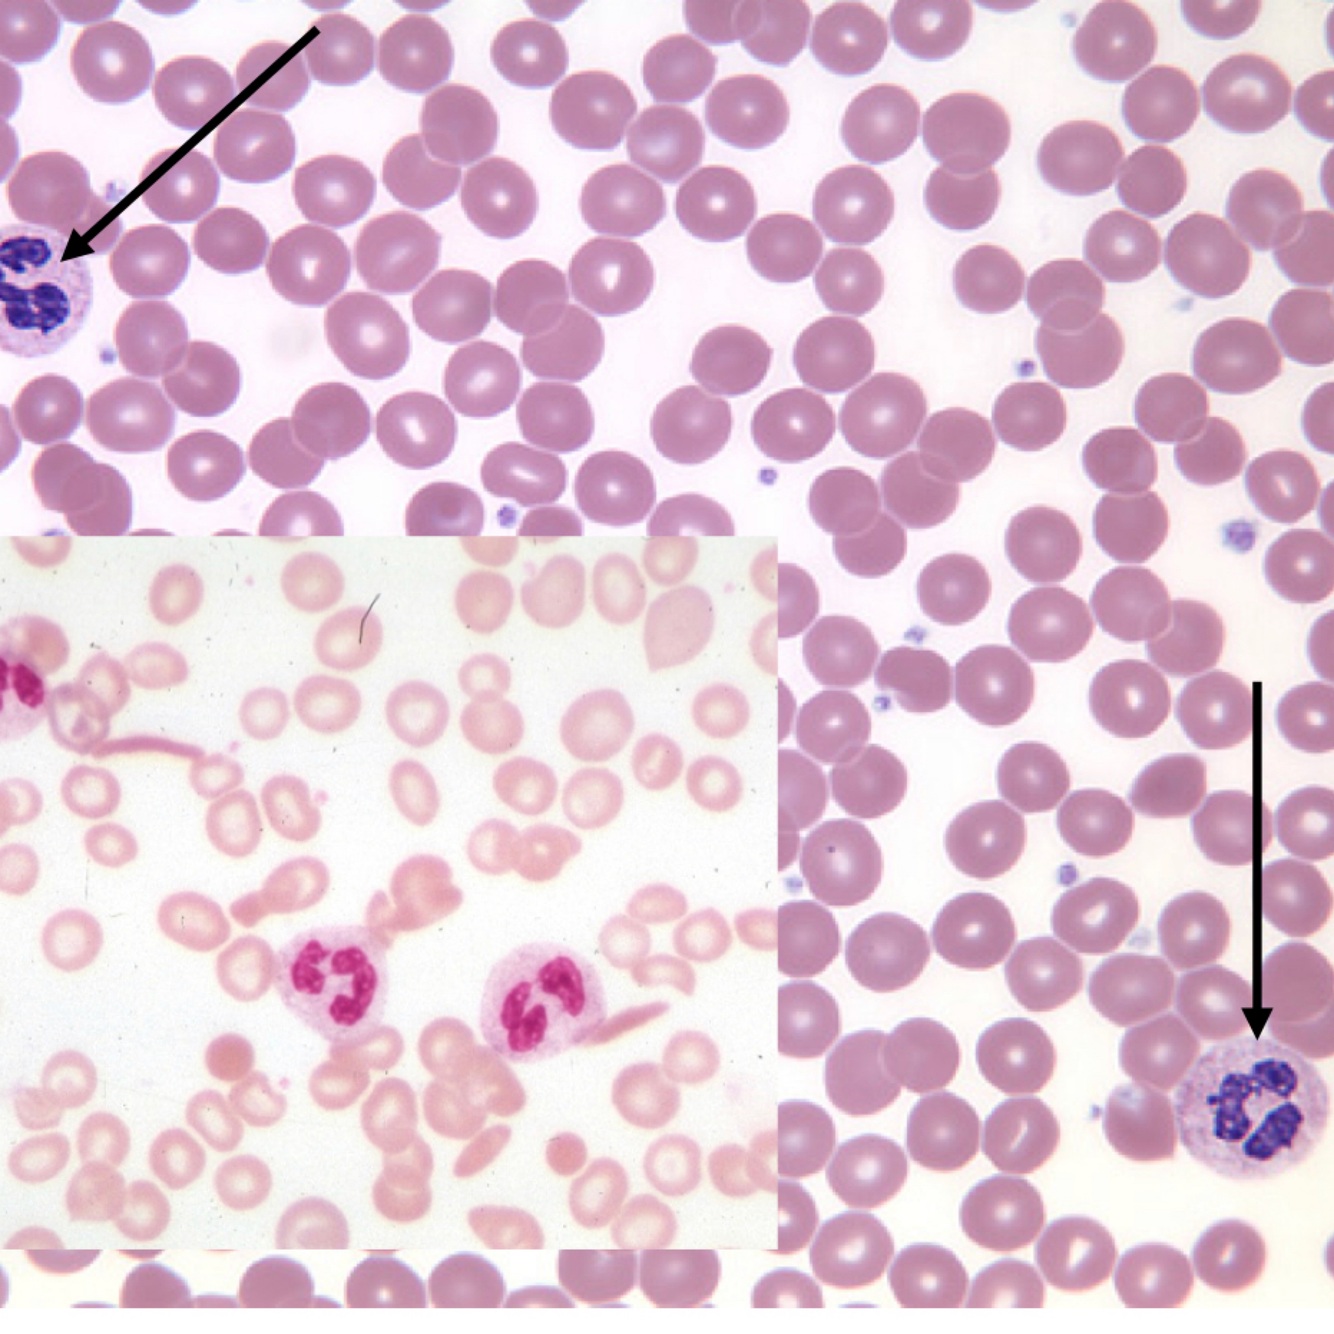
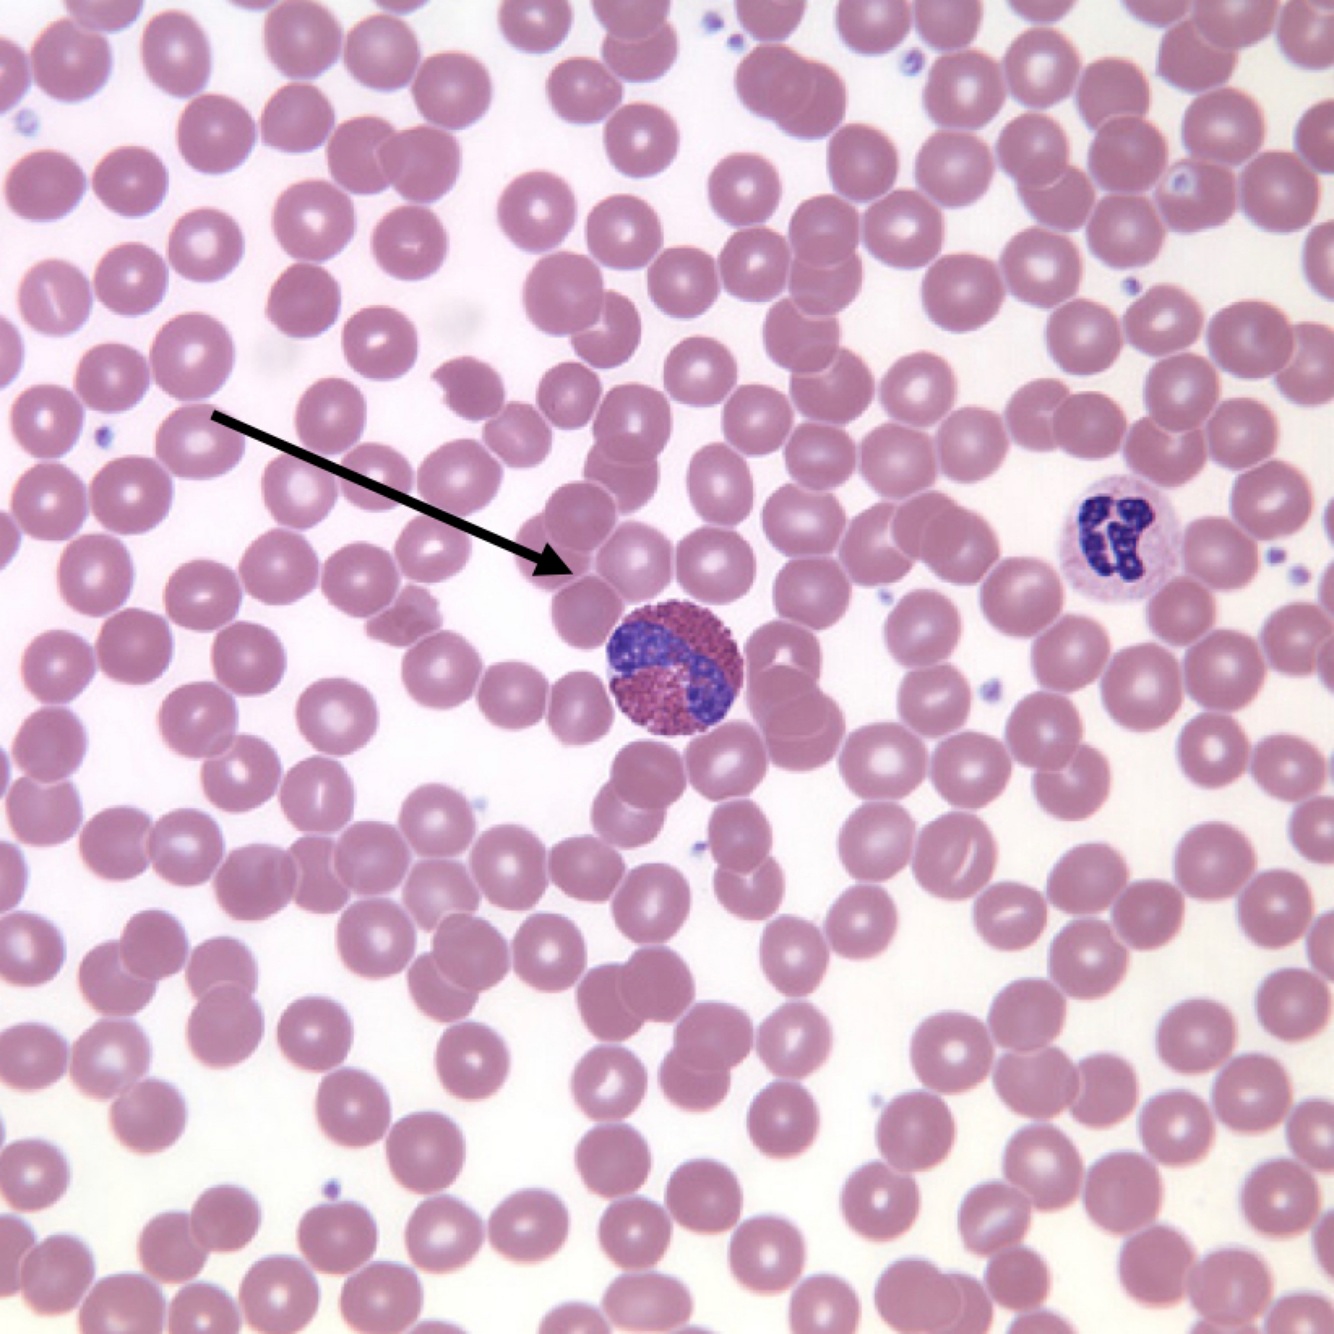
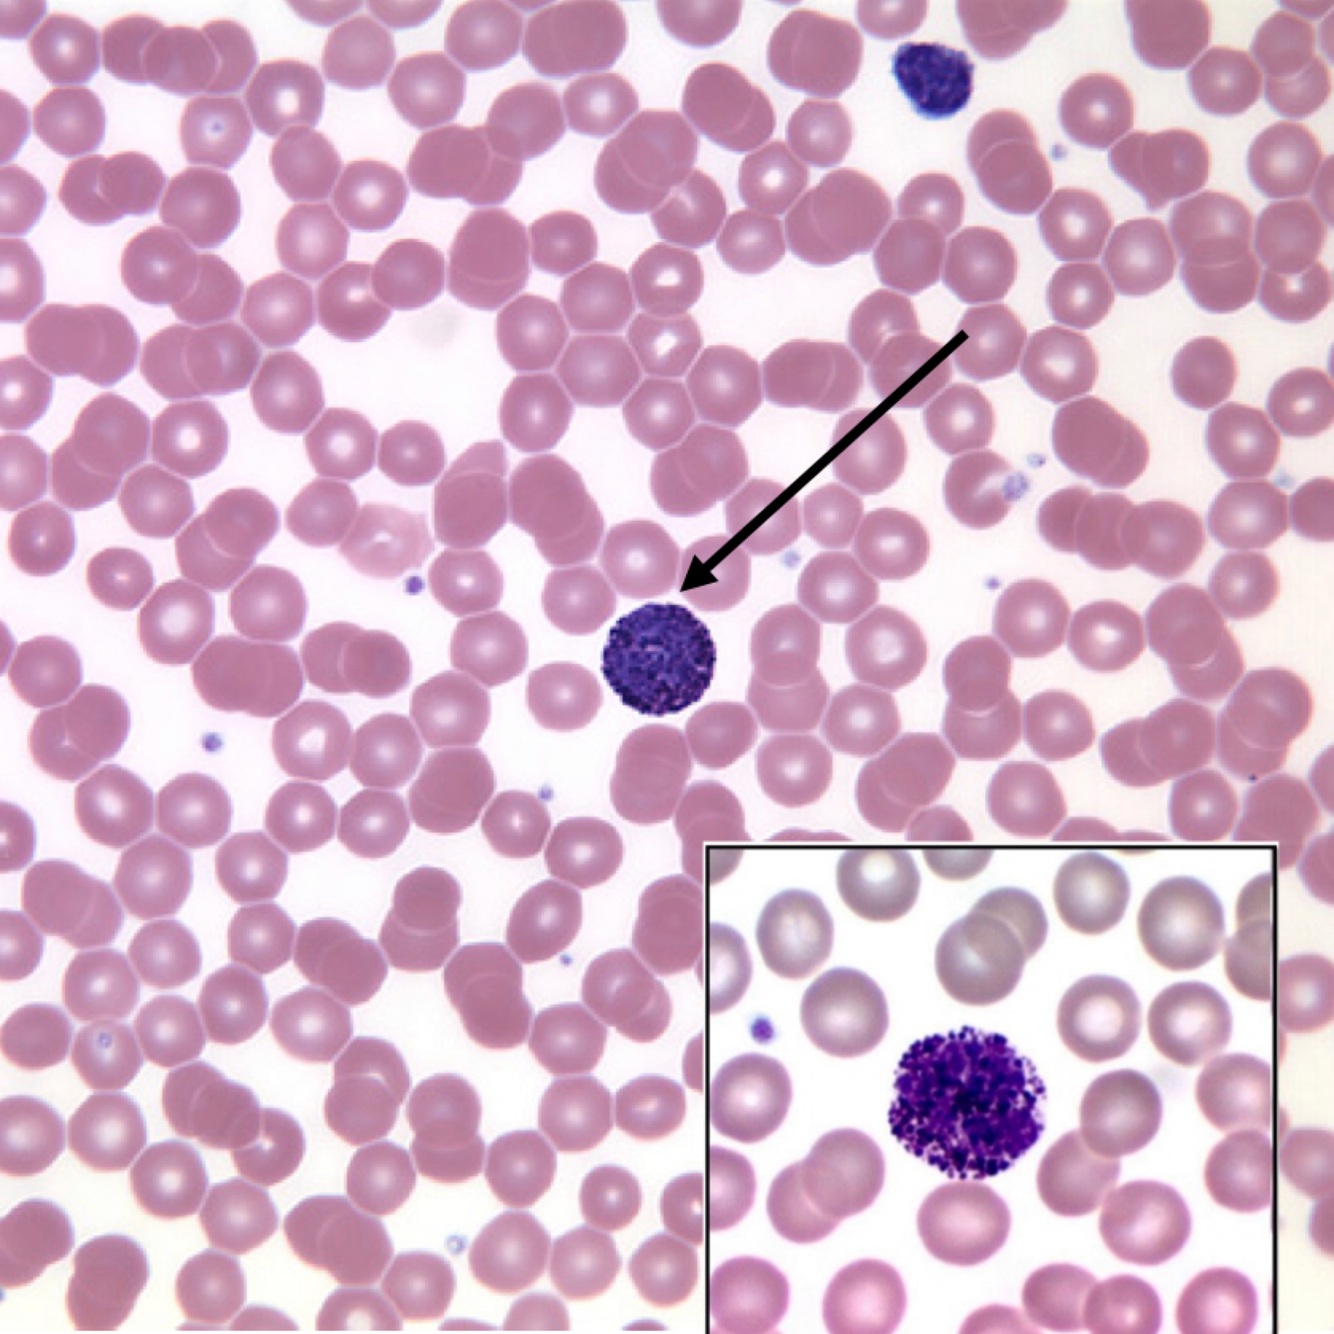
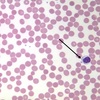
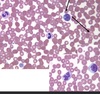

What type of tissue is Blood
Connective
What is the Non-living fluid matrix
Plasma
What is the Living component of blood?
Formed elements
What percentage of plasma is water?
91.5%
What percent of plasma is solutes?
9.5%
What are formed elements
Erythrocytes and Leukocytes
What are Erythrocytes
Red Blood Cells (RBC)
What are leukocytes?
White Blood Cells (WBC)
What is the ratio or RBC, WBC, platelets, and plasma?
RBC=45%
Plasma=55%
WBC and Platelets= >1%
WBC are broken down into two categories. What are they?
Granular Leukocytes and Nongranular Leukocytes
Granular Leukocytes are divided into what sub categories?
Basophils (least common), Neutrophil (most common), and Eosinophil
What categories fall under nongranular leukocytes?
Lymphocytes and Monocytes
What is the function of the RBC.
To carry O2 from the lungs to the body and CO2 from the body back to the lungs.
What is the Buffy coat?
Leukocytes (WBC) and Thrombocytes (Platelets). Makes the >1% of the fluid in centrifuged blood.
What is the function of WBCs?
To fight against infections
Neutrophil’s abundance
60-70%
Eosinophil’s abundance
2-4%
Basophil abundance
> 1%
Granulocyte: Neutrophil
Granulocyte: Eosinophil
Granulocyte: Basophil
What is the function of Neurophils
To fight bacterial infections and to be the 1st line of defense for the body.
What is the function of Eosinophil
Increases during parasites infection and allergies
What is the function of Basophils
Releases histamine and heparin to mediate inflammatory responses.